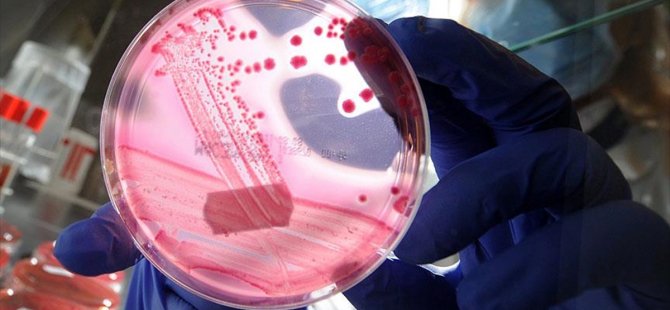
2017'nin dünyayı değiştirecek 10 bilimsel buluşu

Tüm Manşetler
 İspanya Başbakanı:YASALAR İÇİNDE DİYALOGA HAZIRIM22 Aralık 2017 Cuma 18:26
İspanya Başbakanı:YASALAR İÇİNDE DİYALOGA HAZIRIM22 Aralık 2017 Cuma 18:26 Rusya:PYD’NİN KONGREYE KATILIMI ÖNGÖRÜLMÜYOR22 Aralık 2017 Cuma 18:04
Rusya:PYD’NİN KONGREYE KATILIMI ÖNGÖRÜLMÜYOR22 Aralık 2017 Cuma 18:04 Puigdemont:SONUÇLAR BİZE BAĞIMSIZLIK YETKİSİ VERİYOR22 Aralık 2017 Cuma 16:55
Puigdemont:SONUÇLAR BİZE BAĞIMSIZLIK YETKİSİ VERİYOR22 Aralık 2017 Cuma 16:55 Macron:İKİ DEVLETLİ ÇÖZÜME ALTERNATİF YOK22 Aralık 2017 Cuma 15:28
Macron:İKİ DEVLETLİ ÇÖZÜME ALTERNATİF YOK22 Aralık 2017 Cuma 15:28 DÜNYAYI DEĞİŞTİRECEK 10 BİLİMSEL BULUŞ22 Aralık 2017 Cuma 12:43
DÜNYAYI DEĞİŞTİRECEK 10 BİLİMSEL BULUŞ22 Aralık 2017 Cuma 12:43 MOSKOVA'DAN BAĞDAT'A 'DİYALOG' ÇAĞRISI22 Aralık 2017 Cuma 12:04
MOSKOVA'DAN BAĞDAT'A 'DİYALOG' ÇAĞRISI22 Aralık 2017 Cuma 12:04 Katalonya’daBAĞIMSIZLIK YANLILARI ÇOĞUNLUĞU SAĞLADI22 Aralık 2017 Cuma 11:46
Katalonya’daBAĞIMSIZLIK YANLILARI ÇOĞUNLUĞU SAĞLADI22 Aralık 2017 Cuma 11:46 Trump ısrarlı:DESTEK VEREN ÜLKELERE ÖZEL DAVET!22 Aralık 2017 Cuma 11:35
Trump ısrarlı:DESTEK VEREN ÜLKELERE ÖZEL DAVET!22 Aralık 2017 Cuma 11:35 Erdoğan:KARARI MEMNUNİYETLE KARŞILIYORUZ22 Aralık 2017 Cuma 00:20
Erdoğan:KARARI MEMNUNİYETLE KARŞILIYORUZ22 Aralık 2017 Cuma 00:20 Lavrov'dan'SURİYE ULUSAL DİYALOG KONGRESİ' AÇIKLAMASI22 Aralık 2017 Cuma 00:16
Lavrov'dan'SURİYE ULUSAL DİYALOG KONGRESİ' AÇIKLAMASI22 Aralık 2017 Cuma 00:16 İsrailBM'NİN KUDÜS KARARINI KINADI22 Aralık 2017 Cuma 00:12
İsrailBM'NİN KUDÜS KARARINI KINADI22 Aralık 2017 Cuma 00:12 RUSYA'DAN S-400 AÇIKLAMASI21 Aralık 2017 Perşembe 23:45
RUSYA'DAN S-400 AÇIKLAMASI21 Aralık 2017 Perşembe 23:45 BM'deKUDÜS TASARISI 128 OYLA KABUL EDİLDİ21 Aralık 2017 Perşembe 21:01
BM'deKUDÜS TASARISI 128 OYLA KABUL EDİLDİ21 Aralık 2017 Perşembe 21:01 ERDOĞAN'DAN TRUMP'A KUDÜS RESTİ21 Aralık 2017 Perşembe 18:51
ERDOĞAN'DAN TRUMP'A KUDÜS RESTİ21 Aralık 2017 Perşembe 18:51 AYM'denSELAHATTİN DEMİRTAŞ'A RET21 Aralık 2017 Perşembe 16:34
AYM'denSELAHATTİN DEMİRTAŞ'A RET21 Aralık 2017 Perşembe 16:34 Suriye konulu8. ASTANA TOPLANTISI BAŞLADI21 Aralık 2017 Perşembe 14:52
Suriye konulu8. ASTANA TOPLANTISI BAŞLADI21 Aralık 2017 Perşembe 14:52 '31 MİLYON KİŞİ BANKALARA BORÇLU'21 Aralık 2017 Perşembe 14:22
'31 MİLYON KİŞİ BANKALARA BORÇLU'21 Aralık 2017 Perşembe 14:22 Rusya:SURİYE KONGRESİ'NİN TARİHİ BELLİ DEĞİL21 Aralık 2017 Perşembe 13:05
Rusya:SURİYE KONGRESİ'NİN TARİHİ BELLİ DEĞİL21 Aralık 2017 Perşembe 13:05 DEMİRTAŞ’TAN ‘YUVARLAK MASA’ ÖNERİSİ21 Aralık 2017 Perşembe 11:48
DEMİRTAŞ’TAN ‘YUVARLAK MASA’ ÖNERİSİ21 Aralık 2017 Perşembe 11:48 103 yıl sonraKAYBOLAN DENİZALTI BULUNDU21 Aralık 2017 Perşembe 11:11
103 yıl sonraKAYBOLAN DENİZALTI BULUNDU21 Aralık 2017 Perşembe 11:11 BM'DEN KÜRDİSTAN'A İTİDAL ÇAĞRISI21 Aralık 2017 Perşembe 11:01
BM'DEN KÜRDİSTAN'A İTİDAL ÇAĞRISI21 Aralık 2017 Perşembe 11:01 KatanlanlarKADER SEÇİMİ İÇİN SANDIK BAŞINDA21 Aralık 2017 Perşembe 10:14
KatanlanlarKADER SEÇİMİ İÇİN SANDIK BAŞINDA21 Aralık 2017 Perşembe 10:14 Trump'tanKUDÜS OYLAMASI ÖNCESİ MALİ YARDIM TEHDİDİ21 Aralık 2017 Perşembe 00:08
Trump'tanKUDÜS OYLAMASI ÖNCESİ MALİ YARDIM TEHDİDİ21 Aralık 2017 Perşembe 00:08 AB'DEN 'BİTCOİN' UYARISI20 Aralık 2017 Çarşamba 21:57
AB'DEN 'BİTCOİN' UYARISI20 Aralık 2017 Çarşamba 21:57 DanimarkaSIĞINMACI ALMAMAK İÇİN YASA ÇIKARTTI20 Aralık 2017 Çarşamba 17:40
DanimarkaSIĞINMACI ALMAMAK İÇİN YASA ÇIKARTTI20 Aralık 2017 Çarşamba 17:40 Kudüs Latin Patriği:KUDÜS'ÜN STATÜSÜNE SAYGI GÖSTERİLMELİ20 Aralık 2017 Çarşamba 17:20
Kudüs Latin Patriği:KUDÜS'ÜN STATÜSÜNE SAYGI GÖSTERİLMELİ20 Aralık 2017 Çarşamba 17:20 KÜRDİSTAN'DA İKİ PARTİ HÜKÜMETTEN ÇEKİLDİ20 Aralık 2017 Çarşamba 15:50
KÜRDİSTAN'DA İKİ PARTİ HÜKÜMETTEN ÇEKİLDİ20 Aralık 2017 Çarşamba 15:50 'IRAK GÜÇLERİ MAHMUR'A GÜÇ YIĞIYOR'20 Aralık 2017 Çarşamba 15:26
'IRAK GÜÇLERİ MAHMUR'A GÜÇ YIĞIYOR'20 Aralık 2017 Çarşamba 15:26 Hewler ile Bağdat arasındaki'KRİZİN ÇÖZÜMÜ İÇİN ÇABA GÖSTERİYORUZ'20 Aralık 2017 Çarşamba 14:54
Hewler ile Bağdat arasındaki'KRİZİN ÇÖZÜMÜ İÇİN ÇABA GÖSTERİYORUZ'20 Aralık 2017 Çarşamba 14:54 Rosneft:BAĞDAT’IN KIZGINLIĞINA KULAK ASMAYACAĞIZ20 Aralık 2017 Çarşamba 14:25
Rosneft:BAĞDAT’IN KIZGINLIĞINA KULAK ASMAYACAĞIZ20 Aralık 2017 Çarşamba 14:25
Tüm Hakları Saklıdır © 2009 İlke Haber | İzinsiz ve kaynak gösterilmeden yayınlanamaz.
Tel : 0532 261 34 89
Tel : 0532 261 34 89
